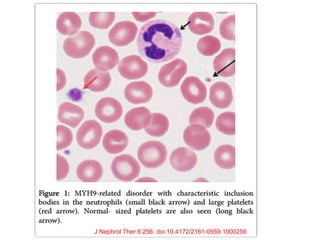
J Nephrol Ther 6:256. doi:10.4172/2161-0959.1000256

1. Familial hematuria refers to hereditary kidney diseases that cause microscopic or gross hematuria. Alport syndrome is a common cause and is a progressive hereditary glomerular basement membrane disease caused by mutations in collagen IV genes.
2. Angiotensin-converting enzyme inhibition is the first-line treatment for Alport syndrome to delay progression to end-stage renal disease, with angiotensin receptor blockers and aldosterone inhibition as second-line treatments.
3. Renal transplantation is curative for patients who progress to end-stage renal disease from Alport syndrome and results in good transplant outcomes. Long-term follow up is important given the risk of progression in familial